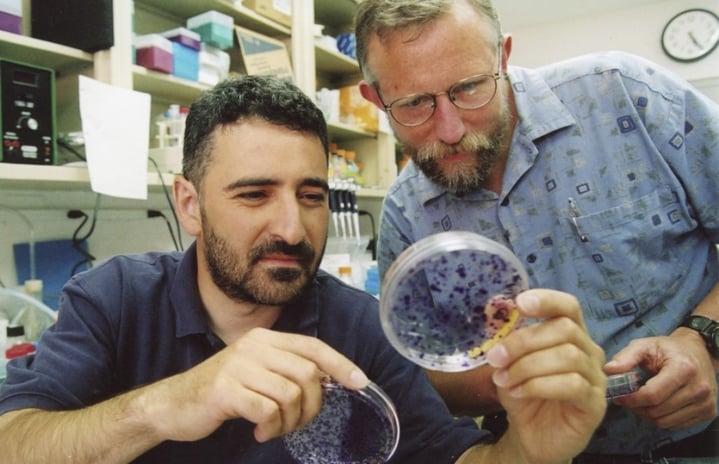
Featured Image

Recent winners of the Nobel Medicine Prize
Here is a list of the winners of the Nobel Medicine Prize in the past 10 years following the announcement of the 2020 award on Monday:
This 2017 handout photo obtained October 5, 2020, courtesy of The Rockefeller University shows Charles M. Rice(R) with a student in a lab. - Americans Harvey Alter and Charles Rice together with Briton Michael Houghton won the Nobel Medicine Prize on October 5, 2020 for the discovery of the Hepatitis C virus, the Nobel jury said.The three were honoured for their "decisive contribution to the fight against blood-borne hepatitis, a major global health problem that causes cirrhosis and liver cancer in people around the world," the jury said. Thanks to their discovery, highly sensitive blood tests for the virus are now available and these have "essentially eliminated post-transfusion hepatitis in many parts of the world, greatly improving global health", the Nobel committee said. (Photo by Handout / The Rockefeller University / AFP) /
Copyright © 2026 The Edition
- Terms of Use
- Privacy Policy
- Code of Ethics
- Editorial Policy
- Contact
Copyright © 2026 The Edition
mihaaru.com